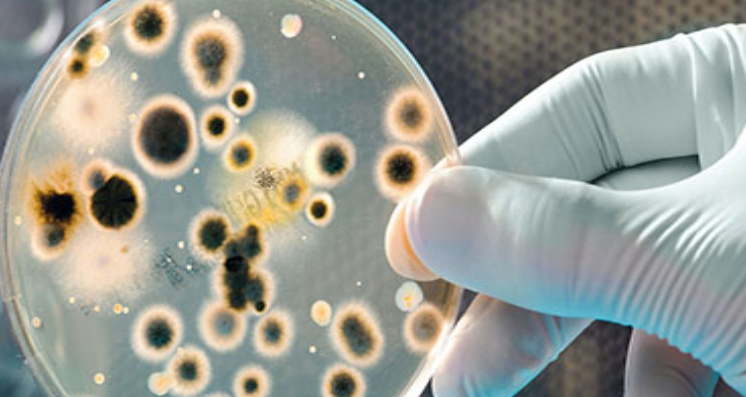
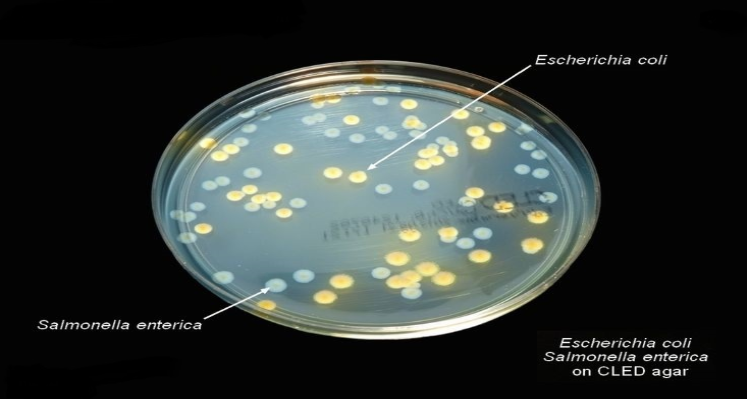

There is a wide range of marijuana testing methods that are used in order to assess potency, quality and safety so that consumers can be adequately informed. There are a few procedures, though, that are common to the cannabis industry. Cannabis potency details are helpful in knowing the exact CBD and THC levels in each product or marijuana plant.
Our Cannabinoid Potency Analysis furnishes you with quantitative intensity estimations of the major cannabinoids in your flowers, concentrates, tinctures, topicals, edibles and different cannabis-imbued items. Our strategy takes into account the recognition and evaluation of:
THCa
Delta 9-THC
Delta 8-THC
THCv
CBDa
CBD
CBDv
CBN
CBC
CBGa
CBG
Our Cannabinoid Potency Analysis furnishes you with quantitative intensity estimations of the major cannabinoids in your flowers, concentrates, tinctures, topicals, edibles and different cannabis-imbued items. Our strategy takes into account the recognition and evaluation of:
THCa
Delta 9-THC
Delta 8-THC
THCv
CBDa
CBD
CBDv
CBN
CBC
CBGa
CBG